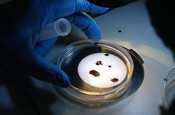
Havalar ısındı ortaya çıktı! İki kişi hastanelik oldu

Hakkari'de 26 Nisan’da dereye düşerek kaybolan 8 yaşındaki Osman Taş’ın cansız bedeni, kaybolduğu noktaya yakın bölgede 4 gün süren aramaların ardından bulundu.
Abone olHakkari’nin Şemdinli ilçesinde dereye düşerek kaybolan 8 yaşındaki Osman Taş’tan acı haber geldi. Yufkalı köyü Korgan mezrasında 26 Nisan’da dengesini kaybederek dereye düşen ve akıntıya kapılarak gözden kaybolan küçük çocuk için başlatılan arama kurtarma çalışmaları 4 gün boyunca aralıksız sürdü.
AFAD, Jandarma Arama Kurtarma (JAK), UMKE, belediye ekipleri ve Şemdinli Arama Kurtarma Derneği’nin yanı sıra Van’dan gelen dalgıç polisler de çalışmalara destek verdi. Bölge halkının da katıldığı aramalar, dere yatağı ve çevresindeki alanlarda yoğunlaştırıldı.
CANSIZ BEDENİ KÖPRÜ ALTINDA BULUNDU
Ekiplerin yürüttüğü çalışmalar sonucunda Osman Taş’ın cansız bedeni, kaybolduğu yere yakın bir noktada, köy içerisindeki köprü altında bulundu.
Taş’ın cenazesi, otopsi işlemleri için Şemdinli Devlet Hastanesi morguna kaldırıldı. Olayla ilgili inceleme sürüyor.